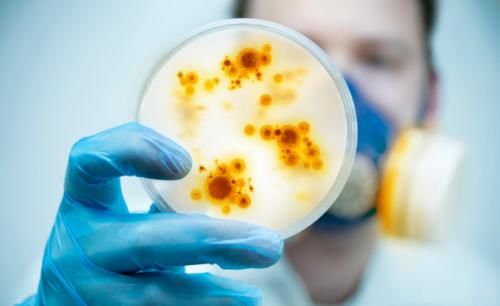
甲肝|这6种传染病,可通过粪口传播,特别是最后2个,宝妈们要格外注意

甲肝|这6种传染病,可通过粪口传播,特别是最后2个,宝妈们要格外注意
文章插图
【 甲肝|这6种传染病,可通过粪口传播,特别是最后2个,宝妈们要格外注意】说到“粪口传播”这个概念,倒是有几种常见的传染病真的就是通过这种途径传染人的。所以,我们去公共卫生间的时候,依然不能放松警惕,特别是儿童人群。接下来,我们就来看看哪些常见传染病史通过粪口传播的吧!
1、什么叫粪口传播
所谓的粪口传播,是指传染病病人的粪便或呕吐物中,存在活的传染性疾病的病原体(细菌或病毒),这些病原体再接着污染了食物和水等,然后再进入人体的消化道,就把其他人感染了。我们老百姓的口头禅“病从口入”,就是对这个粪口传播的比较通俗的说法。

文章插图
2、哪些疾病可通过粪口传播?
粪口传播的传染病还是挺多的,常见的有甲肝、戊肝、伤寒、霍乱、手足口病,还包括一些寄生虫病,比如绦虫病、蛲虫病、蛔虫病。
A、甲肝,在大便的时候,体内的病毒会随着大便排出,如果此时甲肝患者如厕后不洗手,他的手上就可能沾有病毒,接着他们可将病毒传播到手所接触的任何东西上,包括食物、水和其他人。
B、戊肝,在大便的时候,特别是贫困的国家和地区,粪便中的病毒会把水源给污染,如果水源的卫生消毒过滤工作没有做好,饮用这样的水源就可能会被戊肝病毒传染。
PS:大便别想多了,乙肝和丙肝病毒,并不通常这些途径传播哦!
C、伤寒,是一种发热型的疾病,是由伤寒沙门菌引起的细菌感染所致,除了发热还通常伴有腹痛和寒战。伤寒患者如果在接触食物前不洗手,就可以把细菌传播到烹饪的食物中。同样,排出的大便进入供水系统,这些水也未煮熟的话,也会传染他人。
D、霍乱,也是一种通过摄入被霍乱弧菌污染的食物或水而被感染的疾病,主要的症状是呕吐和腹泻。
PS:所以,平时建议大家要喝煮过凉开水,不能直接喝自来水,就是这个道理。

文章插图
E、手足口病,是一种会导致口、手、足和臀部发生皮肤溃疡的传染性疾病,引起手足口的病毒可存在于鼻部的黏液、唾液、溃疡中液体和粪便的残迹传播。
F、寄生虫病,就是我们小时候容易得的肠道传染病,由于当时的卫生条件差,也没有勤洗手的好习惯。所以,还记得当时都吃过的宝塔糖吗,就是专门来杀灭肚子里面的这些虫子的,这种疾病也是会通过粪口传播的。
PS:所以,洗手对于预防这类的疾病,是多么的重要!
3、新冠病毒是否通过粪口传播?
之前,有研究者在部分省份报告的确诊患者粪便标本中监测到病毒核酸阳性,当时仅仅是提示新冠肺炎有粪口传播的可能性,但不能确定能不能通过进食被病毒污染的食物或水而引起感染或传播。不过,最新版的诊疗方案中,传播途径删除了这些内容,这是不是代表新冠病毒不能通过粪口传播呢?我想至少现在是不会通过粪口传播。
4、疫情结束后要继续保持良好卫生习惯
所以,通过这次疫情,我们不断学习了很多传染病相关的知识,接下来疫情介绍以后,我们要继续把良好的卫生习惯给保持下去。比如保持手卫生,饭前便后、接触容易污染的物品后要洗手,水果和蔬菜食用前要清洗干净,不要吃生食,蔬菜肉类要吃熟的,水果最好是剥皮吃,切过生食的刀和切菜板要清洗,不要交叉使用道具,要喝开水不喝生水,上完厕所要先盖上马桶再冲马桶等。
- 张艺谋|张艺谋讲狙击手和长津湖的区别 你怎样看待这两部电影
- 到了孕晚期,这几个“卸货”的信号,孕妈们要注意
- 天使科普:这些表现是孩子智力低下的早期信号,家长可以注意了!
- 那些让父母省心的孩子,100%都具有这项能力
- 现实|一儿一女,你将来会把财产平分吗?这位老人的做法,值得学习
- 时间|认清一个男人对你的心,就看这四个时刻就足够了,过来人都懂
- 付柯炳|爸爸姓“付”,妈妈姓“柯”,给娃上户口,民警:这名酒后取的?
- 胡里|爸爸姓“周”,给五胞胎取名自认好记,民警:喝了多少酒取这名?
- 凤九|宝妈沉迷追剧,给娃取名“凤九”,宝爸听后:我这姓,合适吗?
- 准妈妈们|怀孕后别忙着高兴,这件事要趁早做,不然以后生孩子医院都不接收